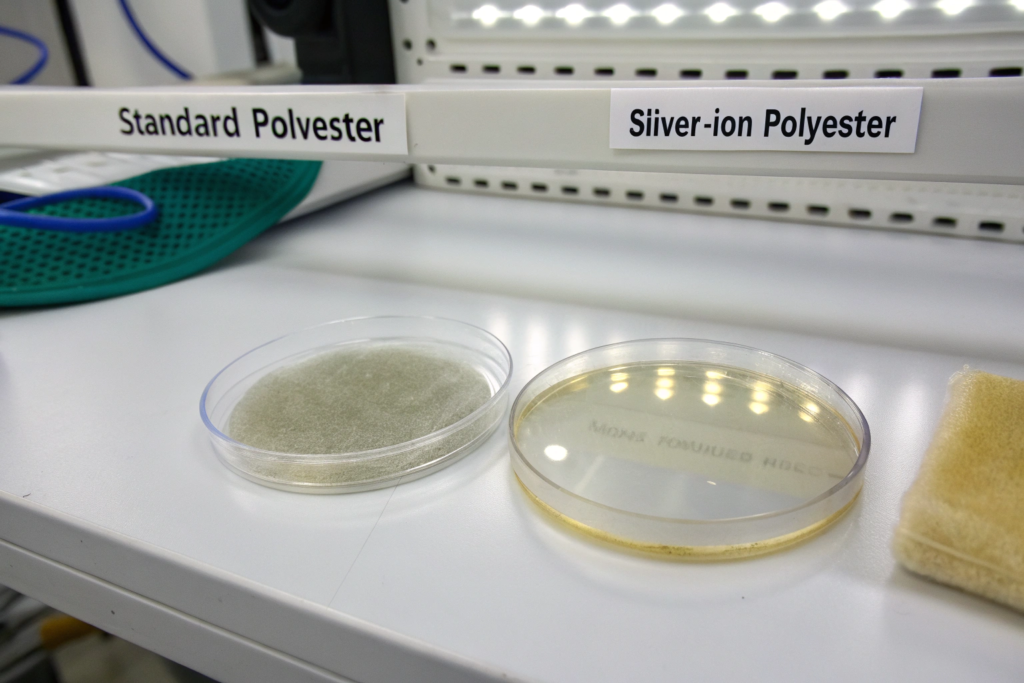

Your child's favorite hoodie starts to smell funky after one wear at the playground. Your performance leggings hold onto sweat odors even after washing, making you hesitate before hitting the gym again. This isn't just about freshness—it's about fabric hygiene, skin health, and product longevity. But with so many "antibacterial" claims on the market, how do you know which technologies actually work and are safe for sensitive skin or high-performance use?
The best antibacterial fabrics for sportswear and kids wear combine effective, durable, and skin-safe technologies integrated into high-performance fibers. Leading choices include silver-ion infused polyesters, copper-oxide embedded fibers, and chitosan-treated natural fabrics. The "best" depends on balancing efficacy against specific bacteria, durability through washes, breathability, environmental impact, and compliance with strict safety standards like OEKO-TEX Standard 100 for children's products.
As a developer supplying technical fabrics to global athletic and children's brands, I've tested countless antibacterial treatments. I've seen a major European kids wear brand recall a line due to skin irritation from an improper antibacterial finish, and I've watched a yoga apparel brand triple their repeat sales after switching to our odor-control fabric. The difference lies in understanding the science behind the claims. Let's break down what truly works and what you should specify for your next line.
How Do Different Antibacterial Technologies Actually Work?
Antibacterial function isn't magic; it's chemistry and physics applied at the fiber level. Different technologies work through distinct mechanisms: contact-killing, leaching, or barrier creation. Understanding this is key to selecting the right one for your application.
1. Metal-Based Technologies (Silver, Copper, Zinc):
- Mechanism: Oligodynamic effect – Metal ions (Ag⁺, Cu²⁺) disrupt bacterial cell walls and interfere with enzyme functions, preventing reproduction.
- Forms: Can be embedded in polymer chips before fiber extrusion (most durable), coated onto yarns, or applied as a finish to fabric.
- Pros: Broad-spectrum efficacy, relatively durable, good for synthetics.
- Cons: Potential for environmental leaching if not well-bonded, higher cost for embedded versions.
2. Natural Biopolymers (Chitosan):
- Mechanism: Derived from crustacean shells, chitosan's positively charged molecules attract and bind to negatively charged bacterial cell walls, disrupting them.
- Forms: Often applied as a fabric finish, but can be integrated into fibers.
- Pros: Biodegradable, skin-friendly, inherently hypoallergenic.
- Cons: Durability through washes can be a challenge if not cross-linked properly; not suitable for vegans.
3. Chemical Finishes (Quaternary Ammonium Compounds, Triclosan derivatives):
- Mechanism: Disrupt bacterial cell membranes.
- Forms: Topical fabric finishes.
- Pros: Potent and inexpensive initially.
- Cons: Major drawback: Many are being phased out due to concerns over skin irritation, bacterial resistance (e.g., Triclosan), and environmental persistence. Not recommended for kids wear.
4. Physical Structures (Micro-rough surfaces, Lotus-effect):
- Mechanism: Creating fiber surfaces at the nano-scale that physically prevent bacterial adhesion, making it easier to wash them away.
- Forms: Engineered during fiber extrusion or via special finishing.
- Pros: No chemicals involved, purely mechanical.
- Cons: May not kill bacteria, only reduces adhesion; efficacy can diminish as the surface wears.
For high-sweat sportswear, silver-ion embedded polyester is a top choice due to its wash durability. For organic kids wear brands, chitosan finishes on organic cotton are preferred for their natural origin. A deep dive into textile chemical finishing journals reveals ongoing innovation in this field.

Which Technology Lasts Through 50+ Washes?
Durability is the true test. A treatment that washes out after 5 cycles is useless. Here’s how they compare:
- Built-in (Embedded) Technologies: Silver or copper ions embedded into the polymer matrix before the fiber is spun offer the best durability. The antibacterial agent is part of the fiber itself, so it lasts the lifetime of the garment. We test this per AATCC Test Method 100 or ISO 20743. Our in-house silver-ion polyester retains over 99% bacterial reduction after 50 industrial washes.
- Strong Bond Finishes: Advanced chitosan or certain durable cationic finishes that chemically bond to fiber surfaces can survive 30-50 home washes if applied correctly.
- Topical Coatings: Basic finishes that sit on the fabric surface typically degrade significantly after 10-20 washes.
Always ask your supplier for third-party test reports showing antibacterial efficacy after repeated washing (e.g., after 5, 20, and 50 washes). A reputable mill will have this data. For a Danish children's school uniform brand, we provided AATCC 100 test reports showing our copper-oxide treated cotton jersey maintained a 98% reduction of S. aureus and E. coli after 50 washes. This data won the contract. Resources like the SDC (Society of Dyers and Colourists) articles often discuss wash-fastness testing.
Are Natural Antibacterial Fibers Like Bamboo and Hemp Effective?
There's a lot of marketing hype here. Bamboo rayon and hemp have some inherent antibacterial properties due to bio-components like "bamboo kun" and lignin, but the effect is mild and inconsistent. The process of turning bamboo into viscose rayon often strips away much of the natural kun. Any significant antibacterial effect in commercial bamboo fabric usually comes from an added chemical finish, not the fiber itself.
Hemp is more breathable and moisture-wicking than cotton, which creates a less hospitable environment for odor-causing bacteria to multiply—this is an indirect effect. For reliable, certified antibacterial performance in natural fibers, you need a verified treatment like a silver-chitosan hybrid or a copper oxide application. Assuming a "bamboo" label means odor-free is a common and costly mistake.
What Are the Top Fabric Choices for Sportswear?
For sportswear, antibacterial function must not compromise performance. The fabric must still excel in moisture-wicking, breathability, stretch, and durability. The technology should be integrated to handle high sweat and friction.
1. Silver-Ion Embedded Polyester or Nylon: The industry workhorse. Perfect for leggings, sports bras, running shirts, and socks. Look for polyester with 0.5%-1% silver-ion content by weight in the masterbatch. It offers excellent durability, moisture management, and reliable odor control. Brands like Lululemon and Under Armour have used variants of this for years. We developed a lightweight, 4-way stretch version for a cycling apparel brand that became their best-selling base layer.
2. Copper-Infused Performance Fabrics: Copper has similar efficacy to silver and is gaining traction for its proven anti-fungal properties (great for socks and footwear linings). Copper oxide particles can be embedded in polyester. Some studies, like those cited in sports medicine research, suggest copper may also aid in skin recovery.
3. Treated Merino Wool Blends: Naturally antimicrobial and temperature-regulating. For premium sportswear, merino wool (even as a 20-30% blend with polyester) provides excellent odor resistance. The key is to ensure the wool is fine and machine-washable. This is a favorite for hiking and trail running gear.
4. Advanced Polyester with Moisture-Wicking + Antibacterial Dual-Finish: Some of the best fabrics combine a hydrophilic antibacterial treatment with a moisture-wicking construction. The treatment pulls sweat into the fiber where the antibacterial agent works, while the knit structure disperses it quickly for evaporation.
Critical Consideration: Ensure the antibacterial treatment does not clog the fabric's pores or reduce breathability. This is a common flaw in cheap topical coatings. Always test for air permeability (ASTM D737) and moisture vapor transmission rate (MVTR) on the finished fabric.
How to Balance Antibacterial Properties with Breathability?
This is the key engineering challenge. A heavy coating will block air flow. The solution lies in fiber-level integration and smart fabric construction.
- Choose the Right Base Fabric: A loose, mesh-like knit will be breathable even with a finish. A dense, heavy knit will not.
- Insist on Integrated Technology: Embedded silver ions in the fiber don't sit on the surface, so they don't create a film that blocks airflow.
- Test, Don't Guess: Request test reports for both antibacterial efficacy (AATCC 100) and air permeability (ASTM D737) on the same fabric sample. Compare them to a non-treated version of the same fabric.
For a high-intensity training wear line, we created a fabric with honeycomb mesh construction using silver-ion yarns only in the high-sweat zones (underarms, back), while the rest used untreated, highly breathable yarns. This "zone technology" optimized both performance and cost. This approach is detailed in technical textile design whitepapers.
Table: Sportswear Fabric Antibacterial Comparison
| Fabric Technology | Best For | Key Advantage | Wash Durability | Cost Level |
|---|---|---|---|---|
| Silver-Ion Embedded Polyester | Leggings, Tees, Socks | Proven, durable, broad-spectrum | Excellent (50+ washes) | $$ |
| Copper-Oxide Polyester/Nylon | Socks, Shoes, Base Layers | Anti-fungal + antibacterial | Excellent | $$ |
| Chitosan-Treated Cotton Blends | Yoga Wear, Casual Sportswear | Natural, skin-friendly | Good (30-50 washes) | $$ |
| Merino Wool Blend (Fine) | Hiking, Trail Running | Natural, temp-regulating | Inherent (lasts fabric life) | $$$ |
| Topical QAC Finish | Low-cost basics | Low initial cost | Poor (10-20 washes) | $ |
What Are the Safest Options for Kids Wear?
For children, safety trumps everything. The fabric must be non-irritating, non-toxic, and ideally, certified for baby and children's use. The focus is on preventing skin irritation and managing mild odors from play, not high-performance sweat.
1. Chitosan-Treated Organic Cotton: The gold standard for premium kids wear. Chitosan is biocompatible, hypoallergenic, and derived from natural sources. When applied to GOTS-certified organic cotton, it creates a fabric that is safe for even the most sensitive skin while providing effective odor control. We supply this to several Scandinavian brands known for their rigorous safety standards.
2. Silver-Ion Embedded Modal or Tencel™: For a softer, more luxurious hand-feel. Modal and Tencel (Lyocell) are regenerated cellulose fibers known for their silk-like softness and breathability. Embedding silver ions at the fiber stage creates a durable, gentle antibacterial fabric perfect for pajamas, underwear, and premium everyday wear.
3. Copper-Infused Cotton: A strong alternative gaining trust. Copper is a natural mineral essential to human health. Copper oxide particles can be embedded in cotton fibers to create a safe, wash-durable option. Ensure it has OEKO-TEX Standard 100, Class I certification (for babies).
Red Flags to Avoid in Kids Wear:
- Triclosan and its derivatives: Banned or restricted in many regions for children's products.
- Vague "Antibacterial" claims without certification.
- Heavy metal-based finishes that are not securely bound, risking skin contact or leaching in saliva (for infants).
A painful lesson: In 2022, a client sourced inexpensive "antibacterial" socks for toddlers from another supplier. The socks used a non-durable, irritating finish. After complaints of rashes, the brand had to issue a recall and destroy inventory—a loss far exceeding any savings on fabric. Now, they mandate OEKO-TEX Standard 100, Class I certification and pediatric dermatologist test reports for all antibacterial claims.

What Certifications Are Mandatory for Kids Antibacterial Fabrics?
Do not compromise here. The required certifications are your legal and ethical shield.
- OEKO-TEX Standard 100, Class I: This is non-negotiable. It certifies the fabric is free from hundreds of harmful substances at levels safe for babies' skin (including any antibacterial agents used).
- GOTS (Global Organic Textile Standard): If using organic fibers, this certifies the organic integrity and responsible processing.
- EPA Registration (for USA): In the United States, if you make a public health claim like "kills 99.9% of bacteria," the antibacterial agent itself may need to be registered with the Environmental Protection Agency (EPA) as a pesticide. Legal guidance is crucial here.
- Dermatologically Tested Report: A human patch test report from a recognized lab proving no skin irritation.
At Shanghai Fumao, our kids wear antibacterial fabrics are always pre-certified with OEKO-TEX Class I. We provide the full test report dossier to our clients, so their compliance teams have seamless documentation. Staying updated on global children's product safety regulations is part of our service.
How to Test for Both Efficacy and Skin Safety?
Your testing protocol must be two-fold:
- Efficacy Testing: Use AATCC 100 or ISO 20743 (Quantitative method) against relevant bacteria like Staphylococcus aureus (skin bacteria) and Klebsiella pneumoniae (sweat odor). Look for >99% (or 2-log) reduction.
- Safety Testing: Human Repeat Insult Patch Test (HRIPT) conducted by an accredited lab. This involves applying the fabric to a panel of human subjects over repeated periods to check for allergic or irritant reactions.
We conduct both tests in our CNAS-accredited lab for our standard antibacterial lines. For a French children's sleepwear brand, we provided a full dossier including HRIPT reports on our chitosan-treated organic cotton interlock. This gave them the confidence to market it as "pediatrician-approved."
How to Source and Specify These Fabrics Correctly?
Navigating the antibacterial fabric market requires precise communication with your supplier. Vague requests lead to unsuitable or non-compliant materials.
Your Sourcing Brief Must Include:
- Intended Use: "Children's pajamas for ages 2-6" or "High-intensity compression sportswear for marathon training."
- Required Certifications: "Must comply with OEKO-TEX Standard 100, Class I" or "ZDHC MRSL Level 3 compliance."
- Performance Specifications: "Antibacterial efficacy: >99% reduction against S. aureus per AATCC 100 after 30 home washes." "Fabric weight: 180-200 GSM."
- Safety & Feel: "Must pass HRIPT. Hand-feel must be soft and non-irritating."
- Testing Requirements: "Provide third-party test reports for efficacy (after 5, 30 washes) and safety prior to bulk production."
Questions to Ask Your Supplier:
- "Is the antibacterial agent embedded in the fiber or applied as a finish?"
- "Can you provide wash-durability test data?"
- "What is the specific active agent (e.g., silver chloride, copper oxide, chitosan of X molecular weight)?"
- "Does this formulation comply with the latest EU REACH SVHC and US EPA regulations?"
When a US-based sustainable kids brand approached us, they had a failed sample from another vendor. By asking these questions, we identified the failure: a cheap topical finish that washed out and failed skin tests. We proposed a switch to our embedded Tencel™ with silver, provided all requested data upfront, and secured a long-term partnership. Forums like Material Exchange can be useful for vetting supplier claims.

What Are the Cost vs. Benefit Trade-Offs?
Antibacterial features add cost, but they also add value and can reduce returns.
- Embedded Technologies: Higher upfront cost (10-30% more than untreated fabric), but long-lasting performance justifies it for premium lines and core styles.
- Quality Finishes: Moderate cost increase (5-15%), suitable for mid-market brands, but require rigorous wash-testing.
- Cheap Finishes: Minimal cost add (<5%), but high risk of failure, customer complaints, and brand damage.
The return on investment comes from customer loyalty, reduced returns due to odor complaints, and the ability to command a higher price point for a technical benefit. For sportswear, it's often a necessity; for kids wear, it's a powerful marketing advantage for parents.
Conclusion
Choosing the best antibacterial fabric requires moving beyond marketing slogans to a forensic examination of technology, durability, safety, and certification. For sportswear, embedded silver or copper in high-performance synthetics offers durable odor control. For kids wear, chitosan-treated organic fabrics or silver-infused Tencel provide the essential balance of safety and efficacy.
The most successful brands treat antibacterial features as a serious technical specification, not a generic add-on. They demand data, certifications, and transparency from their fabric partners, ensuring the final product delivers on its promise to the consumer.
If you're looking to integrate effective, safe, and certified antibacterial technology into your next sportswear or children's collection, we have the expertise and proven fabrics to guide you. At Shanghai Fumao, we develop and test our antibacterial fabrics in-house, providing full transparency from lab reports to compliance documentation. Contact our Business Director, Elaine, to discuss your specific needs and request samples and data dossiers.
You can contact Elaine at: elaine@fumaoclothing.com.